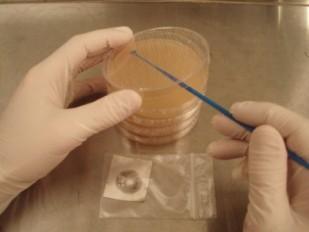

Myzelkultivierung aus Sporen
(Schwierigkeitsstufe 3 – Spezialisten)
Myzelkultivierung aus Sporen ist eine Methode, um Pilzmyzel für eine „Multikultur“ zu gewinnen. Das sichtbare Myzelgeflecht einer Multikultur ist nicht ein und derselbe Pilz, wie z. B. ein Baum, sondern besteht aus vielen einzelnen Lebewesen, die aus den Sporen gekeimt sind. Infolgedessen sind die Fruchtkörper, die aus einer Multikultur entstehen, Fruchtkörper von verschiedenen eigenständigen Organismen, die gleichzeitig auf dem Fruchtungssubstrat gewachsen sind (nicht wie verschiedene Früchte von demselben Baum). In der kommerziellen/professionellen Pilzzucht werden Multikulturen hauptsächlich verwendet, um von vielen verschiedenen Organismen derselben Gattung den Stärksten zu suchen und in Folge mit diesem weiterzuarbeiten.
Empfohlenes Zubehör:
- Sporen (Sporenabdruck oder Sporenspritze)
- Agarplatten in Petrischalen
- Einweg-Impfösen oder Nadelhalter mit Impföse
- Parafilm zum Versiegeln der Petrischalen
- Spiritusbrenner (nur für Metall-Impfösen)
- Gesichtsmaske und Haarnetz
- Latex-Handschuhe
- Flächendesinfektionsmittel
- Händedesinfektionsmittel
- Glove Bag (steriler Arbeitsraum)
Beimpfen der Agarplatten
Um zu verhindern, dass auf den Agarplatten andere Mikroorganismen (Bakterien, Schimmel etc.) siedeln, empfehlen wir, vor einem HEPA-Filter oder in einer Impf-/Glovebox zu arbeiten. Die Arbeitsfläche und die Hände gut reinigen und desinfizieren. Das Tragen von Haarnetz, Gesichtsmaske und Latex-Handschuhen senkt das Kontaminationsrisiko. Da gerade Sporenabdrücke von selbst gesammelten Pilzen oft von Bakterien bewohnt sind, bewährt sich hier der Einsatz von antibakteriellen Agarmedien.

Durch Reiben am Abdruck mittels steriler Impföse werden so lange Sporen aufgenommen, bis die Öse einen Sporenschleier zeigt. Arbeitet man mit Mehrweg-Impfösen aus Metall, muss die Impföse über dem Spiritusbrenner erhitzt werden bis die Spitze glüht. Bevor man die Impföse mit den Sporen in Kontakt bringt, wieder auf Zimmertemperatur abkühlen lassen. Weder Sporen, Impfösenspitze noch Agar mit der Hand berühren oder mit anderen Kontaminationsquellen in Kontakt bringen!

Die mit der Impföse aufgenommenen Sporen werden auf die Agarplatten übertragen. Mit der Impföse ein "S" aus Sporen auf den Nährboden zeichnen. Um das Kontaminationsrisiko möglichst gering zu halten, schnell arbeiten, dabei die Petrischale nur kurz und gerade so weit öffnen, dass man mit der Impföse hineinkommt. Nach dem Auftragen der Sporen die Schale sofort wieder schließen und mit Parafilm versiegeln. Wenn man mit Sporenspritzen arbeitet, genügen einige Tropfen (1-2 ml) der Sporenflüssigkeit für eine Petrischale. Da nicht immer alle Sporen gleich gut keimen, empfehlen wir, mit jedem Abdruck mehrere Agarplatten zu beimpfen.
Üblicherweise werden die Petrischalen mit Datum, Gattung, Strain (Strains sind unterschiedliche Sorten innerhalb derselben Gattung – vergleichbar mit verschiedenen Apfelsorten) und evtl. einer fortlaufenden Nummer beschriftet (Lackstifte oder CD-Marker halten gut auf der Petrischale).
Myzelwachstum
Die fertig beimpften Agarplatten werden für die Wachstumsphase des Myzels an einem sauberen, dunklen Ort bei der für die jeweilige Pilzgattung empfohlenen Temperatur gelagert. Im Brutraum oder -kasten muss für ausreichend Frischluftzufuhr gesorgt werden. Nach einigen Tagen bis zu einer Woche keimen die Sporen aus. Sobald auf der Petrischale rhizomorphe Myzelstränge sichtbar werden, sollen diese selektioniert werden (siehe Anleitung „Selektionierung von Myzelsträngen“).
Literaturnachweis:
„Mycelium running/ How mushrooms can help save the world“, Paul Stamets; Ten Speed Press, Berkeley/Toronto;
„The Mushroom Cultivator: A Practical Guide to Growing Mushrooms at Home", Paul Stamets, Agarikon Press; First Edition (December 1983);
„Growing Gourmet and Medicinal Mushrooms”, Paul Stamets, Ten Speed Press, Berkeley/Toronto;